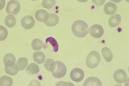

<<次の記事 前の記事>>
2012,05,31, Thursday
author : tokan-eco

春も中盤のこの季節になると、毎年恒例の作業「草刈り」
がやって来ます。今日は水処理施設周辺の刈払い作業を
行いました。ほぼ斜面の為、足場に気を付けながらの作業
です。
雑草の生命力は素晴らしく、刈っても刈ってもみるみる茂
ってきます

が、施設内の美観を保つ為、根気よく安全
に刈り続けます

良く晴れた日の東環に刈払機のエンジン音がこだまする
のがこの季節の風物詩となっています。
中間処理センター 田口
| 今日の東環 |
12:54 PM |
comments (11) |
trackback (0) |
2012,05,30, Wednesday
author : tokan-eco

弊社、井川工場では定期的に除草作業を行っています。
見た目以上に重労働で、斜面などを長い時間刈り続けて
いると次の日に筋肉痛が・・・

ですが刈り終えた
箇所を見るとスカッと小ぎれいになり、気持ちの良いもの
です。
井川工場には見学のお客様も良くいらっしゃるので、
「工場周りもキレイですね」と言ってもらえるように維持し
て行きたいと思います。
中間処理センター 松村
| 今日の東環 |
04:08 PM |
comments (25) |
trackback (0) |
2012,05,29, Tuesday
author : tokan-eco
↓堰堤に刈り込みされた「TOKAN」マーク

5月も終わりに近づき、お客様の搬入台数が増えてきました。
それに伴い再資源化品の選別量も多くなり、特に木くずは破砕
作業を行っても数日後にはヤードが一杯になってしまう程です。
新築工事の活発化で解体が活発化してきたのが要因だと思
います。
最近入社したばかりの新入社員の方々も照りつく日差しの中
、汗を流しながら作業にあたっており、私も今以上にお客様へ
の対応と選別に努力していきたいと思います

中間処理センター 加賀谷
| 今日の東環 |
05:23 PM |
comments (11) |
trackback (0) |
2012,05,28, Monday
author : tokan-eco

シリーズ第3弾は、おそらくブルドーザーよりも見れる機会の
少ない「キャリー」です。
荷物を積んで不整地をガンガン走れる運び屋で、どんな坂道
でも難なく登って行きます

ですが構造上、横転しやすいと
いう難点があり運転には細心の注意が必要です。運転するに
は「不整地運搬車両」の免許が必要で、もちろん弊社の有資格
者が毎日安全に乗りこなしています

(写真では荷台にバスが乗っているように見えるのは錯覚です

)
中間処理センター 信太
| 今日の東環 |
04:39 PM |
comments (20) |
trackback (0) |
2012,05,25, Friday
author : tokan-eco

これからの季節は、「日焼け止め」が必需品ですよね。
ですが、日焼け止めも非常に種類が豊富でお困りではありませんか?
それに、「SPFとPAってなに?」と思う方もおられることでしょう。
そこで今日は、日焼け止めに表示されている「SPF」、「PA」と日焼けの原因、「紫外線」についてご説明します。
日焼けは、紫外線を浴びると起こりますね。
紫外線は、
UVA(長波長紫外線) UVB(中波長紫外線) UVC(短波長紫外線)
に分けられ、UVCは大気中でほとんどなくなるらしいのですが、どうやらUVAとUVBが主な日焼けの原因らしいです。
そして、日焼けの代表的な症状が、
1.皮膚が赤くなり痛みが出る 2.皮膚が黒くなり、皮がむける
ではないでしょうか。
まず、皮膚が赤くなり痛みが出るのは、UVBを皮膚が防ぎきれず、細胞が傷つくためです。
このUVBを防ぐのが、「SPF」です。
通常30分で肌が赤くなる人が、SPF10の日焼け止めを塗った場合、10倍の紫外線量を30分浴びて肌が赤くなるということです。
ここで気をつけて頂きたいのが、「10倍の紫外線量」であって、「10倍の時間」ではないことです。
当然、汗や衣服のこすれで効果は薄れていきますので、こまめに塗りなおすことをお勧めします。
また、数字が大きいほど効果も高いようですが、肌への刺激も強くなります。
普段の生活に合った強さのものを選んでください。
そして次に、肌が黒くなるのはUVAによるものです。
これを防ぐ効果の強さを、PA+ PA++ PA+++ の3段階で表示されています。
+の数が多いほど、黒くなりにくいというものです。
こちらは具体的にどれくらいと説明するのが(私には)難しいので、選ぶ際は+の数を参考にしてください。
ちなみに、サンオイルはUVBを防ぎ、UVAで肌を黒くするものです。
以上の説明でなんとなく選び方がわかって頂けたでしょうか。
ご購入の際の参考になれば幸いです。
中間処理センター 大坂
| 今日の東環 |
02:01 PM |
comments (1) |
trackback (0) |
2012,05,24, Thursday
author : tokan-eco

先日、業務の一環で岩手県に行きました

少し見づらいですが東北道から撮った「岩手山」の写真です。
写真ではなく実際に見ると目の前にそびえ立つ様な存在感
で天気も快晴だった為、上から下までくっきりと見えて絶景
でした。富士山や秋田の鳥海山も良いですが、殆ど雪の無い
真緑の山もなかなかのものです。
この様な「絶景」を残す為、環境保全に勤めたいと思います。
開発センター 神田
| 今日の東環 |
09:26 AM |
comments (1) |
trackback (0) |
2012,05,22, Tuesday
author : tokan-eco

はたらく乗り物シリーズ第2弾は「ブルドーザー」です。
「ブルドーザー」の語源は以前紹介しましたね。
弊社で使用しているブルはコマツ製で、鮮やかな「東環ピンク」
に染まっています。非常にパワーがあり、山になった土砂や廃
棄物もひとたびブルが通るとあっという間に平らな地面になりま
す(と言っても熟練した技術が必要ですが)。
普段良く目にするバックホーと違い用途が限られている為、なか
なかお目に掛かれない乗り物です。というか乗れる機会も殆ど
無い重機なので、ブルに乗れる環境に感謝です。
維持管理センター 高田
| 今日の東環 |
04:46 PM |
comments (26) |
trackback (0) |
2012,05,19, Saturday
author : tokan-eco

今日から弊社処分場に配備された重機などをピックアップして
「はたらく乗り物」と題して紹介します。第一弾は「バックホー」です。
現在国産重機メーカーはキャタピラー、コマツ、日立建機など様々
ですが弊社のメイン機はキャタピラー社製です。
バックホーの処理能力や大きさを表す際に「コンマ4」や「コンマ7」
などと呼び区別しますがこれはバケット(物を持ち上げる手の部分)
の容量がコンマ4であれば0.4㎥(立米)という意味です。
これ一台で「すくう」「ならす」「移動する」「つかむ」など、幅広い用
途に活躍する頼もしい重機です

維持管理センター 北嶋
| 今日の東環 |
04:25 PM |
comments (1) |
trackback (0) |
2012,05,18, Friday
author : tokan-eco

事務所裏のしいたけを収穫に行った人が、
こんな立派なカタツムリを見つけてきました。
昨日まで雨が続いて、すっきりしない毎日でしたが、
このカタツムリにとっては恵の雨なのでしょうね。
子供の頃は手にとって遊んだものですが、
中身はナメクジと同じ種類だと知ってからは可愛さ70%オフ・・
眺めるだけにしておきます。
「毒(?)を持っている」なんて噂もありましたし・・
韓国では、カタツムリの粘液から作る美容クリームなるものが
流行していたそうなのですが、
ナメクジ系をカオに塗るなんて!!と抵抗を感じるのは
私だけではないはず・・・美の道は険しいようです。
テクニカルセンター 村上
| 今日の東環 |
05:26 PM |
comments (3) |
trackback (0) |
2012,05,16, Wednesday
author : tokan-eco

昨年度当社は、夏季、冬季と全県一斉節電行動に参加
しましたが、今年度は秋田県における二酸化炭素排出量
の約2割は民生家庭部門からなっていることから家庭での
節電行動の実践がテーマとなりました。弊社従業者も「節
電宣言エントリーシート」を提出予定しております。
夏季ピーク時における大きな節電効果を期待しています!
テクニカルセンター 長谷川
| 今日の東環 |
02:24 PM |
comments (0) |
trackback (0) |
2012,05,15, Tuesday
author : tokan-eco

弊社水処理施設の調整池へ降りる道路脇の芝桜です。
今年の桜は短期間で散ってしまいましたが、水処理施設の
芝桜は今が満開です。年々大きな集合になってそこだけ華
やかに見えます。気候も良くなって周囲の草も勢い良く伸
びはじめましたが、草に負けずに広がって欲しいと思って
います。
もうすぐ草刈機での除草作業も始めるので、芝桜を刈っ
てしまわないよう注意しながら生育を見守っていきたいと
思います。
統括センター 佐 藤
| 今日の東環 |
04:51 PM |
comments (34) |
trackback (0) |
2012,05,12, Saturday
author : tokan-eco

先日紹介しました「わらび」に続いて、事務所裏で栽培
している「しいたけ」が収穫の時期を迎えました。
さっそくお昼のお味噌汁の具に登場

大きさもそうですが普段スーパーで買うしいたけよりも
濃い味と香りの強さにビックリ!!
みんなでおいしく頂きました

皆さん、良い週末をお過ごしください

事務センター 阿部
| 今日の東環 |
03:38 PM |
comments (13) |
trackback (0) |
2012,05,11, Friday
author : tokan-eco

もうすぐ母の日ですね

何かと忙しく、普段実家へ帰れていませんが、
母の日はカーネーションを持って母の顔を見に
実家に帰ろうと思います。
いつか自分の子供からも・・と考えると嬉しく
なってきますね

事務センター 越中
| 今日の東環 |
05:12 PM |
comments (0) |
trackback (0) |
2012,05,10, Thursday
author : tokan-eco

春を感じる桜が満開をむかえたGWだったのにあいにくの天気と
連日の強風であっという間に花が散ってしまい、一気に山々に緑
が増えように思えます。
連休明けに出勤すると弊社のまわりの田んぼでは田植えの前
準備、『しろかき』が始まっていました!
天気の良い時は出勤時に朝日が映り、帰宅時には夕日が水鏡
に反射しています。田植えが始まるまでのほんのわずかな光景
ですが弊社にいらした際は徐行運転をしながら今だけの景色を
楽しんでみてください。
事務センター 加賀屋
| 今日の東環 |
05:21 PM |
comments (4) |
trackback (0) |
2012,05,09, Wednesday
author : tokan-eco

去年ブログで紹介してから、早いもので1年・・・
今年もツバメ達が帰ってきてくれました♪
ですが、先日の強風で巣が壊れてしまい、せっか
く帰ってきてくれたツバメ達は巣を探し彷徨ってい
る姿がみられます。
可哀相ですが、こればかりは作ってあげることが
できないですからね・・・。
今年で見納めかと思うと、ちょっと寂しいです

事務センター 内海
| 今日の東環 |
11:33 AM |
comments (1) |
trackback (0) |
2012,05,08, Tuesday
author : tokan-eco

連休明け山の木々に緑がだいぶ目立つようになりました。
弊社のまわりは山の幸がとても豊富なとてもよい環境に恵
まれております。お昼休みに外に出てみると短時間でこん
なにワラビが採れました。
店頭に並ぶ山菜よりずっと新鮮なものが目の前ですぐ手
に入る贅沢さ。山の恩恵に感謝です。
皆さんも旬の食材食べていますか?
事務センター 伊藤
| 今日の東環 |
04:30 PM |
comments (17) |
trackback (0) |
2012,05,07, Monday
author : tokan-eco
GW期間中は悲惨な事故や災害などが連日ニュースで流れて
いましたが、最大9連休を過ごされた方もいたと思います。
連休後半はあいにくの雨模様でしたが、隣県に遊びに行ったり
、お友達のお家に遊びに行ったり、買い物へ出掛けたりと毎日充
実した日々を過ごしまていました。皆さんはどういった休日を過ご
されましたか?
お家でゆっくりされた方、お出掛けした方さまざまだとは思いま
すが、気持ちを切り替えて今日からまた仕事を頑張っていきまし
ょう!!
事務センター 細部
| 今日の東環 |
05:52 PM |
comments (24) |
trackback (0) |
2012,05,02, Wednesday
author : tokan-eco

皆様、ゴールデンウイークはどの様にお過ごしですか?
先週の土曜日からお休みの方もいらっしゃるのではない
でしょうか

さて弊社も明日5月3日(木)より6日(日)までゴールデン
ウイーク休業とさせて頂きます。皆様にはご不便をお掛け
致しますが、7日(月)より元気に通常営業致しますので、
宜しくお願い致します

開発センター 平川
| 今日の東環 |
04:39 PM |
comments (28) |
trackback (0) |
2012,04,27, Friday
author : tokan-eco

弊社の敷地内にある桜の木がついに開花しました

冬は例年になく雪が多く、3月中旬まで氷点下の日も
ありましたが、ここ最近は気温が上がり一気に咲き乱
れました。
やっとここ秋田にも春が訪れた気がします

物流管理センター 塚田
| 今日の東環 |
01:06 PM |
comments (1) |
trackback (0) |
2012,04,26, Thursday
author : tokan-eco

4月始めまで雪が降っていましたが、暖かい陽射しが多くなり
昨日は気温が20度を超えました。が、今日は一転してまたまた
強風に悩まされました

秋田市でも桜のつぼみがピンク色になり、24日に平年より6日
遅く桜の開花が発表されました。山里にある弊社でも沢や斜面
に春を告げる「ふきのとう」が土から花茎を出し、土や緑の色が
増え、春が来ました

中間処理センター
| 今日の東環 |
05:25 PM |
comments (15) |
trackback (0) |
2012,04,25, Wednesday
author : tokan-eco

写真は先日、東日本を襲った爆弾低気圧によって
木がなぎ倒された様子です。
様々な所で被害があり、屋根が飛んだりハウスが
倒壊したり、電柱が折れたりと・・・。
我が家では小屋の壁が剥がれたり、小規模でしたが
ダメージを負いました。弱り目に祟り目とは言ったもの
で、数日前の強風でさらに悪化してしまいました

ちなみに倒れていた木は数日後にはキレイにカット
され丸太に変身していました

中間処理センター 嶋崎
| 今日の東環 |
04:36 PM |
comments (16) |
trackback (0) |
2012,04,24, Tuesday
author : tokan-eco

2000年のこの日、ナイジェリアでマラリア撲滅国際会議で
この日を「アフリカ・マラリア・デー」として制定しました。
2008年から世界保健機関が「世界マラリアデー」として実施
されています。
我々も日々色々な業務を行っているので、病気や怪我に
気をつけて精進していきます。
中間処理センター 田口
| 今日の東環 |
04:59 PM |
comments (13) |
trackback (0) |
2012,04,23, Monday
author : tokan-eco

弊社では毎週月曜日の朝、従業者全員による「全体朝礼」
があります。
進行としては、各部署からの伝達や一人ひとりが今週の目
標を発表したり・・・etc。
そして最後を飾るのは従業者全員での発声確認。
「オーライ!オーライ!」
「こんにちは、いらっしゃいませ!」
「ありがとうございました!」
月曜日の朝はこんな声が飛び交いますが、いらしたお客様は
驚かないでくださいね

中間処理センター 磯崎
| 今日の東環 |
05:28 PM |
comments (9) |
trackback (0) |
2012,04,21, Saturday
author : tokan-eco

井川町に在るエコプラネット井川工場は完全屋内型の
処理施設になっています。その為、搬入物を降ろした際
にどうしても塵やホコリが出てしまい、それが地面に厚く
溜まってしまいます。今まではモップやほうきで清掃して
いたのですが広い場内のためかなりの時間と労力を必
要とし、悩みの種でした。
そこに先月、画期的なアイテムが導入されました

自走式スイーパーと手押し式スイーパーの計3台で、走ら
せるだけで地面の塵やホコリを撒き散らすことなく吸い込
み、みるみるうちに場内をキレイにしてくれる優れもので
す。同じ悩みをお持ちの方は是非試してみては??
(因みに家庭用もあるようです)
中間処理センター 松村
| 今日の東環 |
01:00 PM |
comments (10) |
trackback (0) |
2012,04,20, Friday
author : tokan-eco
雪が降る心配もほぼ無くなり?新築等に伴う解体が活発化
しているせいか、最近では弊社へ搬入されるお客様も増えて
きました。搬入されたものを選別する訳ですが、特に木くずの
搬入量は相当なもので、一日で山のようになります

暖かいを通り越して汗ばむ位の気候の中、最近入社した新入
社員の方も、額に汗を滲ませながら頑張っています。
花見の季節もやってきて、いよいよ灼熱の夏が待っています

中間処理センター 加賀谷
| 今日の東環 |
05:31 PM |
comments (4) |
trackback (0) |
2012,04,19, Thursday
author : tokan-eco

最近私は、色々な業務を知っておいた方が良いという事
で、普段とは全く畑違いな井川工場の受付け業務を始め
ました。
そもそもパソコンが大の苦手な私には、専門用語やなん
やらで???な事が多すぎて毎日悪戦苦闘の日々

それでも少しずつですが入力スピードや伝票発行は早くな
りました。
お客様にご迷惑をお掛けする事もあると思いますが、自分
のスキルアップの為にも日々努力して行きます。
中間処理センター 三浦
| 今日の東環 |
04:17 PM |
comments (8) |
trackback (0) |
2012,04,18, Wednesday
author : tokan-eco

雪もなくなり、桜の開花まであと少しですね。
しかし、空からは雪ではないものが降ってくる時期です。
「黄砂」です。
洗濯物は汚れるし、車は黄色くなるし・・・。
私は自分で車を洗いますが、洗った次の日の朝に車を見るとがっかりします・・・。
ですが、黄砂も自然環境に重要な気象現象らしいのです。
土を肥やしたり、プランクトンの栄養源になったりする・・・らしいです。
自然は様々な現象がバランスを取り合って成り立っているんでしょうね。
でも車が汚れるのは悲しい・・・。
中間処理センター 大坂
| 今日の東環 |
04:51 PM |
comments (8) |
trackback (0) |
2012,04,17, Tuesday
author : tokan-eco
いよいよ春めいた陽気が続くようになりました。
弊社管理型処分場では、お客様が廃棄物を投棄する
場所が埋立ての状況によって日々変化します。
その為、朝の全体ミーティングの際に担当者から危険
箇所の説明や安全作業の喚起の他、当日の投棄場所
の指示があります。この指示に従って作業やお客様の
誘導を行います。この指示を良く聞かず作業にあたると
パニック状態になってしまいますので、皆メモを取りなが
ら真剣に聞いています。
お客様にストレスの掛からない様、弊社の従業者一同
スムーズ・確実・元気な誘導をモットーとしています

中間処理センター 鈴木
| 今日の東環 |
04:59 PM |
comments (10) |
trackback (0) |
2012,04,16, Monday
author : tokan-eco

弊社搬入路の大掛かりな舗装工事も終盤に差し掛かり
見違える程に走りやすくなりました。
その搬入路には一部、S字?のカーブがあるのですが、
何やら色の違う舗装作業が進められていました。工事関
係者の方に話を聞くと、普通の路面よりねじれに強く耐久
性にも優れ、一部色が違うことによって運転者に速度抑制
を促す効果もあるとの事。言われれば市内の大きな道路で
もよく見かけますね。
道路工事の方々の仕事ぶりを見ているとさすがプロと唸
ってしまいます。毎日、ご苦労様です!
中間処理センター 佐々木
| 今日の東環 |
07:11 AM |
comments (2) |
trackback (0) |
2012,04,13, Friday
author : tokan-eco

先日、東北を襲った爆弾低気圧による強風で県内では
屋根がそのままそっくり吹き飛ばされた家屋や、農業用
ビニールハウスが壊滅的な被害を受けました。
その影響は弊社にもあり、重機や車両を修理する際の
建屋の屋根が吹き飛ばされました

しばらくは天候が悪かったり風が強い日が続き、修理
できずにいましたがやっと春らしい天候になり、修理を行
いました。
高所作業なので細心の注意を払い、作業を進め無事
修理完了!その他も細かな被害がありますが順次修繕
を進めて行きます

中間処理センター 信太
| 今日の東環 |
06:59 AM |
comments (3) |
trackback (0) |
2012,04,12, Thursday
author : tokan-eco

どこの会社でもそうでしょうが、弊社の朝はお客様が
早朝から並んでいる事が多く、大変忙しいんです

必ず事務所前に1~2人が出て無線のやり取りをしな
がら誘導を行っています。現場との無線のやり取りが
スムーズに行かないとお客様の車両同士がお見合い
してしまったり処分場内に入った車両が迷子になって
しまったり・・・。
そんな事が無いようにお客様とのコミュニケーション
も大切にしてスムーズに進むように心がけています。
維持管理センター 高田
| 今日の東環 |
09:50 AM |
comments (1) |
trackback (0) |
2012,04,11, Wednesday
author : tokan-eco

長らく搬入されるお客様にご迷惑をお掛けしていました
搬入路と場内主要道路の改修舗装工事がほぼ終了し、
以前の痛んでいた道路から比べ、大変走り易くなりました。
県道からの搬入路も以前は大型車両のすれ違い時には
片側交互通行のようになっていましたが、道路幅員を大幅
に拡張した事で、見違える程スムーズになりました。
まだ細部に仕上げ工事が少々残っていますが、真新しい
道路に見合う様、場内清掃もしっかり行います

維持管理センター 北嶋
| 今日の東環 |
09:42 AM |
comments (19) |
trackback (0) |
2012,04,10, Tuesday
author : tokan-eco

4月にはいって10日も経つのに、
春を感じられない日が続いていましたが、
今日は、久しぶりに春らしい一日になりました。
毎年お花見の季節は肌寒いまま、あっという間に過ぎて、
じっくり桜を眺めることもなく、
車で通りすがりの桜を見かけるのが関の山でしたが、
今年は会社の食堂から「しだれ桜」が見られそうです。
日本人ですので、満開の桜を見るとござを敷きたくなるのですが、
仕事の合間の息抜きにとどめておかなくてはと考えつつ、
満開の「しだれ桜」、とても楽しみにしています。
テクニカルセンター 村上
| 今日の東環 |
08:12 PM |
comments (1) |
trackback (0) |
2012,04,09, Monday
author : tokan-eco

記録的な豪雪や、最近では爆弾低気圧による強風の為
今冬は皆さん大変苦労されたことでしょう。
話は変わりますが弊社従業者は作業用として全員安全靴
を着用しています。冬は防水の為安全長靴(長靴の先に鉄芯
が入ったもの)ですが雪も溶け、これからの時期は写真の様
なタイプを履きますが、さらに釘を踏んでも貫通しない鉄板を
中敷として入れます。仕事柄、鋭利なものや、重量物を扱う
作業が多いので、この安全靴はまさに「商売道具」の一つと
なっています。
開発センター 神田
| 今日の東環 |
10:57 AM |
comments (21) |
trackback (0) |
2012,04,07, Saturday
author : tokan-eco

弊社敷地内に高圧受電の為のキュービクルが設置され
ました。これまで水処理施設は、EG-200自家発電機によ
り電力を供給を行ってきましたが、燃料の高騰と発電機
の老朽化によるメンテナンスコストを考慮して、電力会
社からの供給に切り替えることになりました。
自家発電機は、昨年の震災時の停電や先日の強風による
停電で大活躍でしたが、今後は停電時のバックアップ用
として維持管理してゆくこととしました。
電力事情が逼迫している状況ではありますが、水処理
施設のランニングコストは大幅に改善されることが期待
されます。
統括センター 佐 藤
| 今日の東環 |
05:32 PM |
comments (21) |
trackback (0) |
2012,04,06, Friday
author : tokan-eco

新年度がスタートしましたが、秋田の天候は晴々としません

台風並みの「爆弾低気圧」は3日夜から4日にかけて北上を続け、東北
地方を中心に停電が相次ぐなど、各地に爪痕を残しました。
弊社でも昨日夕方、ようやく電力が復旧いたしました。停電時は、非常
用発電機での業務対応をしました。迅速な緊急事態対応は日頃の訓練
の賜物だった思います。
もうすぐ桜が咲くというのに雪もちらついた今週ですが、季節は春!
新年度『きょうの東環』スタートです!
テクニカルセンター 長谷川
| 今日の東環 |
10:19 AM |
comments (7) |
trackback (0) |
2012,03,29, Thursday
author : tokan-eco

雪の無くなった田んぼでは通勤時にこんな風景が見られます。
私は、この会社に入社するまでは田んぼに白鳥がいるのを見
たことがなかったのでかわいらしくてとても感動しました。天気
の良い日はとてものどかで、せっせと動く姿はなんとなく水辺
にいる白鳥さんより楽しそうな気がします。
春が来て、もっと暖かくなったら白鳥さんともお別れなのかもし
れません。
事務センター 佐藤
| 今日の東環 |
01:52 PM |
comments (14) |
trackback (0) |
2012,03,26, Monday
author : tokan-eco

この時期、ここ秋田では氷点下を下回ることも無く
日中の気温も10℃くらいまで上がり春らしくなってく
るものですが、写真を見てもお分かりの様にすっかり
冬景色・・・

4月までもう少し。もうひと踏ん張りしてこの冬の寒
さを乗り越えるぞ~

物流管理センター 塚田
| 今日の東環 |
04:47 PM |
comments (1) |
trackback (0) |
2012,03,23, Friday
author : tokan-eco

弊社には様々な重機があり、アタッチメントの種類も豊富に
ある中で、自分のキャリアが短いのもあり写真の様なハサミ
を見るのが始めてでビックリしました

実際に重機に取り付けた姿は、まんま「鳥」です。
重機を始め「働く機械」には自分が見たことも無いようなもの
が沢山あるようです。色々な重機を見てみたいものです。
中間処理センター 嶋崎
| 今日の東環 |
04:54 PM |
comments (11) |
trackback (0) |
2012,03,22, Thursday
author : tokan-eco

1992年(平成4年)の国連総会で決定し、翌1993年(平成5年)から
実施。国際デーの一つです。
地球的視点から水の大切さ、貴重さを世界中の人々が共に見つめ
なおす日。日本では8月1日「水の日」となっているので、この日は「地
球と水を考える日」としています。
弊社でも、水は切っても切れない程大切なものなので、蛇口から水
が出るのを当たり前に思わず、一滴一滴を大切に使用する気持ちを
大事にして行きたいと思います。
中間処理センター 田口
| 今日の東環 |
05:41 PM |
comments (10) |
trackback (0) |
2012,03,16, Friday
author : tokan-eco
毎々格別のご高配を賜り厚く御礼申し上げます。
弊社は明日3月17日より3月20日までの4日間、
社員研修の為臨時休業を頂きます。
3月21日(水)より平常営業致しますので、ご不便
をお掛け致しますが、どうか宜しくお願い致します。
皆様のご来場を従業者一同、心よりお待ち致し
ております


㈱東環 従業者一同
| 今日の東環 |
04:24 PM |
comments (8) |
trackback (0) |
2012,03,15, Thursday
author : tokan-eco

暗くなってくると決まって雪が大量に降ってきます。
今日もまた、朝には驚くほど積もっていました。
今日も夕日が綺麗だったので一枚。
毎日こんな綺麗な夕日を見れればいいですね

中間処理センター 加賀谷
| 今日の東環 |
05:18 PM |
comments (6) |
trackback (0) |
2012,03,14, Wednesday
author : tokan-eco

最近まで雪もすっかり消え、やっと春が到来したと
油断していたらこの天気

冬に逆戻りです。
日中には全て消えるものの、夕方には必ず降って
きて、朝の通勤時には一面の銀世界。
やはり秋田の冬は油断なりませんね。
皆さんも朝夕の通勤時、車の運転には十分気をつ
けてください。
中間処理センター 三浦
| 今日の東環 |
04:57 PM |
comments (17) |
trackback (0) |
2012,03,13, Tuesday
author : tokan-eco

本日より、痛んでいた当社搬入路の改修工事が
開始されました。
お客様には2週間弱の間ご迷惑をお掛けしますが、
改修後にはキレイな搬入路に生まれ変わりますの
で宜しくお願いいたします。
テクニカルセンター 長谷川
| 今日の東環 |
02:22 PM |
comments (7) |
trackback (0) |
2012,03,12, Monday
author : tokan-eco

巷で流行っているインフルエンザ。
我が家でも我が子とおばあちゃんが感染してしまいました。
私も少々熱っぽかったので医者で見てもらったところ陰性
という結果で感染はしていませんでしたが、家の中でも
マスクが必需品となりました。
今年はA型・B型共に流行している様なので、しっかりと
手洗い・うがいを忘れず、流行が去るまで気を抜かずに
過ごしたいと思います。
中間処理センター 鈴木
| 今日の東環 |
05:24 PM |
comments (15) |
trackback (0) |
2012,03,10, Saturday
author : tokan-eco

弊社搬入路にはコウノテヒバが整然と並び、県道から眺める
と目を引き、初めていらっしゃるお客様もすぐに東環とわかるよ
うです。
ここは大型車両も頻繁に往復するのですが、大型同士すれ
違うには少々道幅が狭いようでした。
そこで安全面を考慮し只今搬入路の拡張工事を行っていま
す。ただの拡張工事ではなくコウノテヒバを移動する必要が
あるので造園屋さんに依頼し急ピッチで作業を進めています。
入場されるお客様には少々ご迷惑をお掛けしますがどうか
宜しくお願い致します。
中間処理センター 佐々木
| 今日の東環 |
05:12 PM |
comments (5) |
trackback (0) |
2012,03,09, Friday
author : tokan-eco

重機やトラックなどの車両はそれぞれの会社のイメージカラー
があり、よく見てみると様々なカラーで区別されています。
ここ東環のイメージカラーは創業時より「ピンク」と決まっています。
他ではそうそうお目に掛かれないカラーリングです。
数日前、長年頑張ってもらった一台がお役御免となり新しい重機
と交換になりました。塗りたてのピンクは処分場の中で一際目立っ
ています。そのため、良く目に入るので接触などの事故防止にも
一役かっています。
維持管理センター 高橋
| 今日の東環 |
05:43 PM |
comments (10) |
trackback (0) |
2012,03,08, Thursday
author : tokan-eco

場内での運搬全般に大活躍のこのダンプ。
普段は廃棄物の残渣運搬で場内を駆け回り、ある時は
砕石等を運んだりと無くてはならない存在となっています。
大事に乗っていましたが、最近ハンドルが思うように効
かない現象が起きてきました。大事に至らないように早め
に修理に取り掛かり、1日で修理完了!
今日も何事も無かったかのように場内を駆け回っています


中間処理センター 信太
| 今日の東環 |
05:27 PM |
comments (10) |
trackback (0) |
2012,03,07, Wednesday
author : tokan-eco

弊社では大小合わせ3匹の犬が暮らしています



うち1匹は大きすぎて怖がる方もいる為、首輪に繋いでいますが
残り2匹は広大な敷地の中で放し飼いしています。
朝、従業者の車が続々と出勤すると一目散に駆け寄って、
おねだりを開始します。自宅から持ってきたお菓子の残りを
あげるのが毎朝の私の日課になっています。
おやつをくれる人とくれない人をしっかり区別している様で
くれない人には見向きもしませんが(笑)。
維持管理センター 高田
| 今日の東環 |
05:44 PM |
comments (2) |
trackback (0) |
2012,03,06, Tuesday
author : tokan-eco


今年は全国的な豪雪で、皆さんも苦労された事でしょう。
ここ東環でも雪には降り続く悩まされました

そんな中、広い敷地の除雪に大活躍だったのが「ロータリ
ー除雪車」。どんなに厚い雪でもどんどん飛ばしてくれます。
操作には少々知識と経験を要しますが・・・。
写真右のアップは雪をかく「オーガチップ」という部分。
昨年の春に全て新品に溶接し直しましたが、ほぼワンシー
ズンを終えての磨耗が歴戦の勇姿を物語っています。
これからも頑張ってもらえるように、メンテを怠りません!
維持管理センター 北嶋
| 今日の東環 |
11:48 AM |
comments (2) |
trackback (0) |
<<次の記事 前の記事>>
PAGE TOP ↑